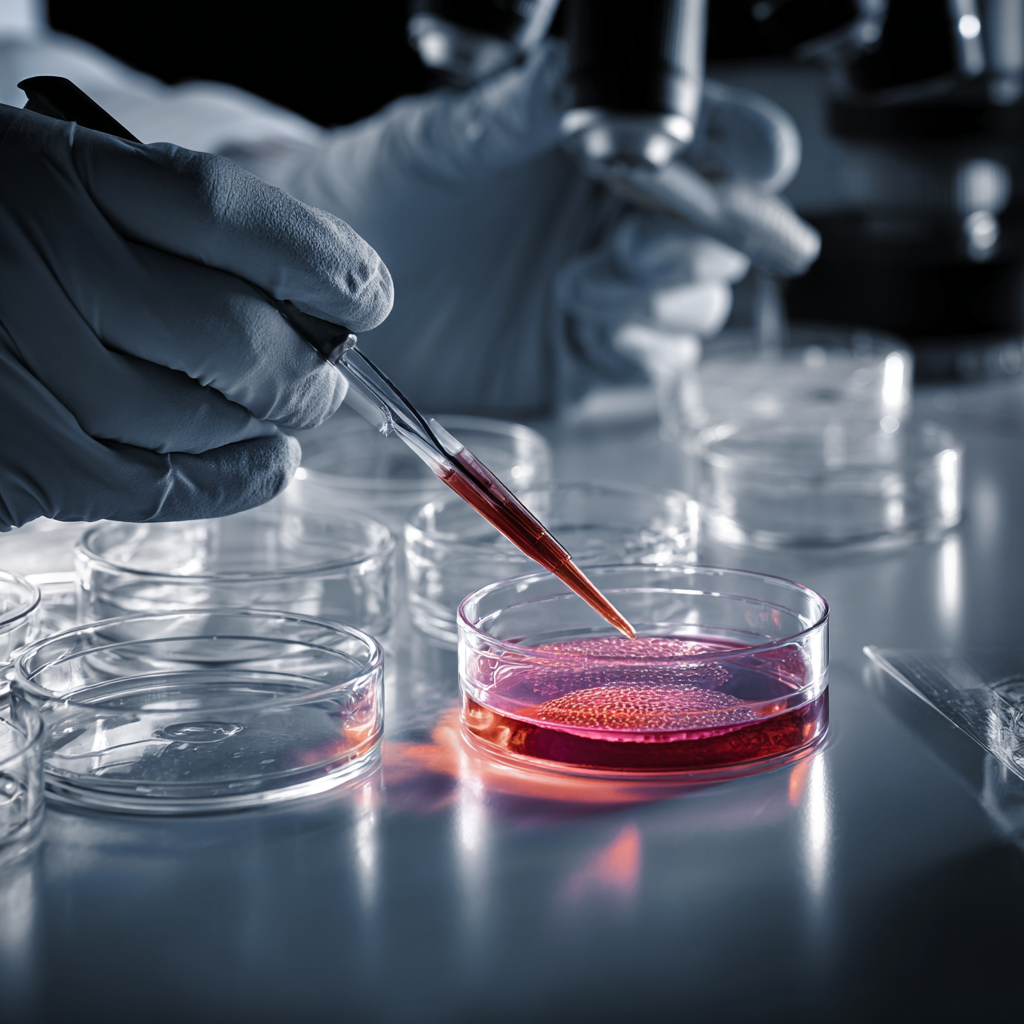

Catalog Number: IB01
Product Format: Frozen or Liquid
Product Volume: 500 mL
Product Usage: Research Use Only. Not for Clinical Use.
Custom Formulations Available
Product Description
A specialized medium optimized for the culture and expansion of immortalized brain vascular fibroblasts (e.g., hBVFs, HBVP-immortalized lines). This formulation supports the unique metabolic and functional needs of cerebrovascular stromal cells, preserving blood-brain barrier (BBB) relevance and promoting angiogenic potential.
Physicochemical Properties
Key Features
✔ Validated for immortalized brain vascular fibroblasts
✔ Maintains BBB-relevant markers:
-
CD13⁺, PDGFR-β⁺, α-SMA⁺ (flow cytometry)
-
Collagen IV and laminin secretion (ICC/ELISA)
✔ Supports angiogenesis assays: tube formation, endothelial co-culture
✔ Pre-screened: mycoplasma, virus, sterility
✔ Available in serum-free or low-serum options
Storage & Handling
-
Liquid Storage: 2–8°C (up to 12 months unopened)
-
Frozen Storage: –20°C (for long-term storage)
-
After Opening: Use within 4 weeks if stored at 2–8°C
-
Avoid freeze-thaw cycles
Recommended Culture Protocol
Subculture Procedure
-
Wash cells with PBS (Ca²⁺/Mg²⁺-free)
-
Detach with cell detachment solution
-
Neutralize with neutralization buffer
-
Centrifuge at 200 × g for 5 minutes
-
Resuspend in fresh IBVF medium and seed at 5,000–10,000 cells/cm² in T25 or T75 flasks
Feeding Schedule
Quality Control – Performance Specifications
| Parameter |
Specification |
| Viability (Trypan Blue) |
≥ 95% |
| Doubling Time |
30–36 hours |
| PDGFR-β Expression (FC) |
≥ 90% positive |
| VEGF Secretion (ELISA) |
200–500 pg/mL/24h |
Safety Testing:
Troubleshooting Guide
| Issue |
Potential Cause |
Solution |
| Poor cell attachment |
Insufficient matrix coating |
Use collagen IV or fibronectin |
| Reduced growth rate |
Growth factor degradation |
Use fresh bFGF aliquots |
| Morphological changes |
High passage number |
Use cells between P5–P20
|
Ordering Information
| Size |
Catalog No. |
| 500 mL |
IBVF-GM500 |
| 1 L |
IBVF-GM1000 |
References
-
Nakagawa et al., J Cereb Blood Flow Metab (2009) – hBVF isolation
-
Sweeney et al., Nature Neuroscience (2019) – fibroblast role in BBB integrity
Related Products
Product Usage
Cells are offered for Research Use Only. Not for Clinical Use.